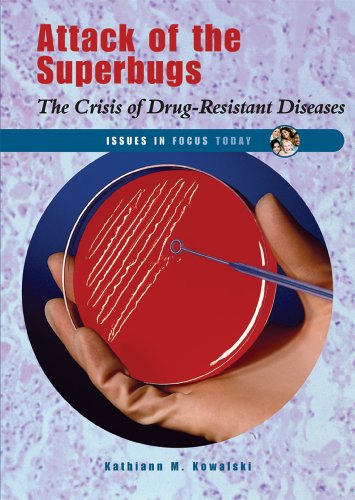
Attack of the Superbugs

Narrow Your Search
Author:"Kowalski, Kathiann M"Date Range+/-
publication+/-
Material+/-
starred+/-
Search Results - Author:"Kowalski, Kathiann M"
20 results
Checks and BalancesA Look at the Powers of Governmentby Kowalski, Kathiann M |
Reviewed In:Horn Book Guide |
||
Evolution on TrialFrom the [cf4]Scopes[cf3] "Monkey" Case to [cf4]Inherit the Wind[cf3]by Kowalski, Kathiann M. |
Reviewed In:School Library Journal |
||
A Pro / Con Look at Homeland SecuritySafety vs. Liberty after 9/11by Kowalski, Kathiann M |
Reviewed In:Horn Book Guide |
||
The [cf4]Earls[cf3] Case and the Student Drug Testing Debateby Kowalski, Kathiann M. |
Reviewed In:School Library Journal |
||
Affirmative actionby Kowalski, Kathiann M. |
Reviewed In:School Library Journal |
||
Attack of the SuperbugsThe Crisis of Drug-Resistant Diseasesby Kowalski, Kathiann M.Providing issues relevant to teens, these full-colour books will present the information needed for research or report writing. Each book presents over 100 pag... |
Reviewed In:School Library Journal |
||
[cf4]Lemon v. Kurtzman[cf3] and the Separation of Church and State DebateDebating Supreme Court Decisionsby Kowalski, Kathiann M. |
Reviewed In:School Library Journal |
||
Civil Libertiesby Kowalski, Kathiann M |
Reviewed In:Horn Book Guide |
||
Taxesby Kowalski, Kathiann M |
Reviewed In:Horn Book Guide |
||
Attack of the SuperbugsThe Crisis of Drug-Resistant Diseasesby Kowalski, Kathiann M |
Reviewed In:Horn Book Guide |



![The [cf4]Earls[cf3] Case and the Student Drug Testing Debate](/images/covers/9780766024786.jpg)


![[cf4]Lemon v. Kurtzman[cf3] and the Separation of Church and State Debate](/images/covers/9780766023918.jpg)